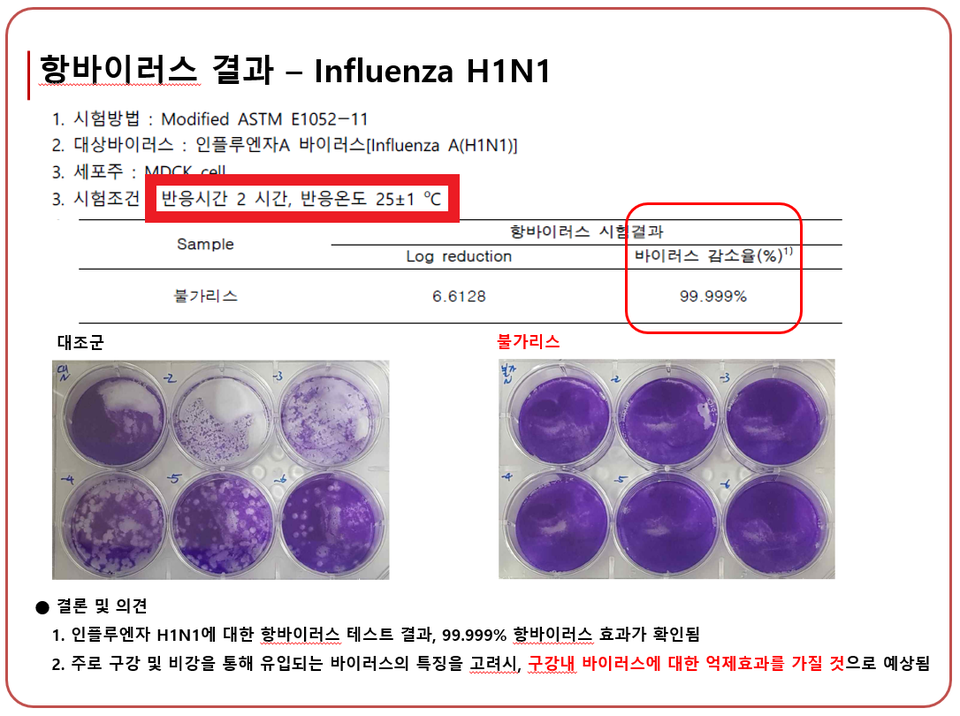
11839_14187_1618.png

불가리스는 '살균제'인가?[팩트체크]
남양유업의 이상한 '코로나19 억제 실험'
남양유업이 자사의 발효유 제품 불가리스가 코로나19 바이러스를 막는 효과가 있다는 연구결과를 발표했다. 남양유업은 "1회 음용량(150mL) 및 구강을 통해 음용하는 점을 감안할 때, COVID-19 바이러스 감소/억제 효과가 있을 것으로 예상됨"이라고 주장했다. 하지만 실험 설계 자체가 이상하다. 뉴스톱이 팩트체크했다.
박종수 남양유업 항바이러스면역연구소장은 13일 서울 중구 중림동 LW컨벤션센터에서 열린 '코로나 시대 항바이러스 식품 개발' 심포지엄에서 "불가리스 완제품이 인플루엔자바이러스(H1N1)와 코로나19에 효과가 있음을 국내 최초로 확인했다"고 주장했다. 이날 심포지엄은 항바이러스 연구 동향 및 발효유의 항바이러스 기능성을 주제로 한국의과학연구원이 주관해 진행했다.
박 소장은 "불가리스 발효유 제품에 대한 실험 결과 H1N1을 99.999%까지 사멸하는 것을 확인했고, 코로나19 억제 효과 연구에서도 77.8% 저감 효과를 확인했다"고 밝혔다.
◈살균제 방식 테스트한 불가리스
이날 발표에서 남양유업이 제시한 실험 방식은 <수정된(Modified) ASTM E1052-11> 이다. ASTM E1052-11 방식은 현탁액에서 살균제의 바이러스에 대한 활성을 평가하는 표준 방식이다.

출처: ASTM International
남양유업은 이 실험법에 대해 "미국의 바이러스 성능평가를 위한 테스트 표준으로 국내 식약처에서도 의료기기용 바이러스 유효성 평가방법으로 사용"이라고 설명했다. 하지만 이는 사실과 다르다. 식약처에선 이 실험법을 의료기기용 살균소독제의 유효성 평가 방법으로 사용한다.
남양유업이 사용한 실험방법은 이렇다. 세포주로 사용된 vero cell(원숭이 폐 세포)에 코로나19 바이러스를 배양한 뒤 불가리스를 넣은 뒤 일정 시간이 지나고 나서 대조군(불가리스를 넣지 않는 쪽)과 비교해 바이러스가 얼마나 억제됐는지를 살피는 것이다.
남양유업이 공개한 실험방식은 의료기기 소독용 살균제의 바이러스 제거 능력을 검증할 때 사용하는 방식과 유사하다. 실험 결과를 풀어쓰면 이렇다. '세포 현탁액에서 살고 있는 바이러스에 불가리스를 접촉시켰더니 77.8%가 억제됐다.'
남양유업은 실험 결과를 바탕으로 "코로나19 억제 효과 연구에서도 77.8% 저감 효과를 확인했다"고 밝혔다.

출처: 남양유업
◈항바이러스 전략과는 다른 실험 방식
남양유업은 심포지엄에서 불가리스의 항바이러스 전략을 공개했다. ▲수용체내 바이러스 침투억제 ▲바이러스 증식 억제를 꼽았다. 구체적으로는 "불가리스내 유효성분이 바이러스의 세포내 부착을 직접 차단(수용체에 대신 부착/ 바이러스에 부착하여 수용체와 접촉 차단)", "불가리스내 유효성분이 바이러스가 이용하는 세포 수용체 (HPSGs)역할을 무력화", "체내 흡수된 불가리스 유효성분이 IFN(인터페론) 활성화하여 바이러스의 복제를 억제하거나 NK세포를 활성화하여 면역력을 증가시킴"이라고 설명했다.
그러나 남양유업이 제시한 "불가리스의 항바이러스 연구결과"는 이 전략의 효과를 설명하는 것과는 결이 다른 내용이다. 단지 개 신장세포, 원숭이 폐세포에 바이러스를 배양하고 대조군과 비교해 얼마나 바이러스를 사멸 또는 억제시키는지를 수치화한 것에 불과하다.
"불가리스의 항바이러스 연구결과"라고 남양유업이 포장한 것은 사실 불가리스를 바이러스에 떨어뜨렸을때 바이러스가 얼마나 억제되는지를 확인한 간단한 실험일 뿐이다.
제대로 된 실험이라면 불가리스를 사람이 마신 뒤 체내 흡수된 유효성분이 인터페론을 얼마나 활성화시키는지, NK성분을 얼마나 활성화시키는지를 보여주고 이에 따른 바이러스 복제 억제 효과와 면역력 증가 효과를 따져야 한다.
◈2시간 동안 입에 물고 있으란 건가?
출처: 남양유업
시험 조건도 실제 소비자들의 음용 습관과는 무관하다. 남양유업은 코로나19 바이러스와 인플루엔자 바이러스로 사멸실험을 했다.
남양유업이 공개한 자료에는 "인플루엔자 H1N1에 대한 항바이러스 테스트 결과 99.999% 항바이러스 효과가 확인됨"이라고 적혀있다.
시험 조건을 살펴보자. 개의 신장세포에 H1N1 바이러스를 배양한 뒤 불가리스를 넣는다. 25(±1)도 조건에서 2시간을 보낸 뒤 불가리스를 넣지 않은 대조군과 비교한다.
불가리스가 바이러스와 접촉해 복제를 막거나 사멸시키는 효능을 보여주는 실험인데 말이 안 된다. 도대체 세상 어떤 사람이 불가리스를 두 시간 동안이나 입에 물고 있는단 말인가? 세상 어떤 발효유가 마신 뒤 두시간 동안 입안에 남아있는단 말인가? 실험 온도 25도는 사람의 체온보다 10도 정도 낮은 조건이다.
◈불가리스, 살균제로 쓰란 건가?
남양유업은 보도자료를 통해 “안전성이 담보된 식품(발효유)에 대한 실험결과로, 1회 음용량(150mL) 및 구강을 통해 음용하는 점을 고려할 때 코로나19 바이러스 감소·억제 효과가 있을 것으로 예상된다”는 결론을 도출했다. 또 “발효유 제품이 인플루엔자와 코로나19에 효과가 있음을 국내 최초로 연구한 것”이라며 연구 의의를 강조하기도 했다.
불가리스는 마시는 발효유이다. 음식은 구강과 식도를 통해 위로 넘어가 소화된다. 당연히 불가리스도 입으로 들어와 식도를 타고 위로 내려간다. 불가리스가 코로나19 바이러스와 접촉해 억제하는 효과가 있다고 해도 구강과 식도로 한정된다.
또 세포 실험은 시료(불가리스)와 바이러스가 접촉해 바이러스를 억제한 결과를 입증하는 방식이기 때문에 접촉시간이 중요하다. 낮은 살균력을 가진 시료라도 오랜 시간 접촉을 시키면 바이러스가 억제 또는 사멸되는 양이 늘어날 수 있기 때문이다.

출처: 남양유업
남양유업은 실험결과를 발표하면서 코로나19 바이러스와의 접촉 시간에 대해서는 공개하지 않았다. 살균제 등에서 살균력 관련 실험을 할 때는 시료와 실험대상을 얼마나 오래 접촉시켰는지가 중요하다. 발효유를 마셨을 때 구강과 식도에 얼마 동안 남아있는지를 고려했을 때 접촉시간은 굉장히 결정적인 요소로 작용한다.
◈질병청, "효과 예상 어렵다"
논란이 일자 질병관리청은 "해당 연구원에서 제시한 결과는 바이러스 자체에 제품을 처리해 얻은 결과이며, 인체에 바이러스가 있을 때 이를 제거하는 기전을 검증한 것이 아니기 때문에 실제 효과가 있을지 예상하기 어렵다"고 밝혔다.
쉽게 풀어서 말하자면 발효유를 마신다고 체내에 들어온 바이러스를 제거할 수 있다고 기대하기 어렵다는 뜻이다.
◈불가리스 실험 결과로 알 수 있는 것들
남양유업의 공개한 실험 결과로 확인할 수 있는 사실은 이렇다. ①인플루엔자 H1N1 바이러스시료(25도 조건)에 불가리스를 떨어뜨리고 2시간이 지나면 바이러스가 99.999% 사멸한다. ②코로나19 바이러스에 불가리스를 떨어뜨린 뒤 일정 시간(얼마인지는 모름)이 지나면 77.78% 억제된다.
이로부터 유추할 수 있는 결론은 이렇다. ①불가리스를 두 시간 동안 입에 물고 있으면 구강에 달라붙어있던 인플루엔자 H1N1의 상당 부분을 제거할 수 있을지도 모른다.(구강 온도는 25도가 아니고 타액이 섞이는 등 시험조건과 달라짐) ②얼마나 걸릴지 모를 시간 동안 불가리스를 입에 물고 있으면 구강에 달라붙은 코로나19 바이러스를 일부 제거할 수 있을지도 모른다.
이와 같은 검증 내용을 바탕으로 뉴스톱은 "1회 음용량(150mL) 및 구강을 통해 음용하는 점을 감안할 때, COVID-19 바이러스 감소/억제 효과가 있을 것으로 예상됨"이라는 남양유업의 주장에 대해 '대체로 사실 아님'으로 판정한다.
일반 소비자들은 남양유업의 실험결과를 인용한 보도를 보고 불가리스 제품을 마셨을 때 코로나19 바이러스를 억제할 수 있을 것으로 오인할 수 있다. 하지만 실험 결과는 제품을 섭취했을 때 일어나는 효과가 아니라 제품을 바이러스에 직접 접촉시킨 뒤 얻어낸 수치이다.
실험조건도 소비자들의 음용습관과는 전혀 다르게 설정돼 있어 일상적인 방법으로 불가리스 제품을 마셨을 때 구강 내 바이러스를 제거할 수 있을지에도 심각한 의문이 제기된다.
이 기사는 팩트체크 전문 미디어 뉴스톱(www.newstof.com)에도 함께 실렸습니다.